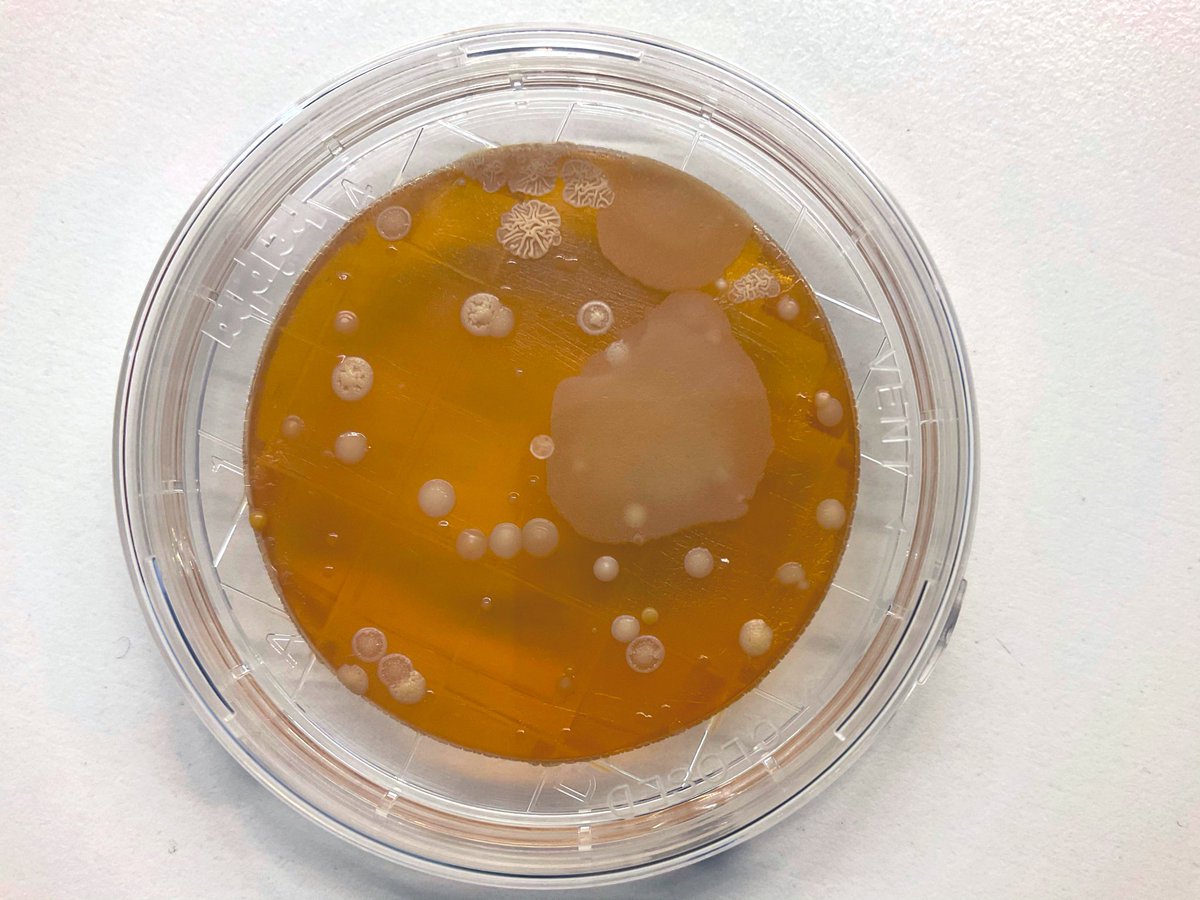
Bacteria + fungi farming with year 8 👩🏼‍🌾🧑🏾‍🌾🧫

Jaz Sillince
@jazsillince
Science Educator - a bunch of cells talking about other cells 💫 Zoologist with a passion for wildlife conservation, animal welfare and herpetology 🦎🐍🐢
ID: 1160879176578150403
12-08-2019 11:42:18
88 Tweet
37 Followers
74 Following


Stunning ancient rainforests in Australia's largest tract of temperate rainforests are threatened by a new heavy metal tailings dump. On Friday, the day after meeting Sussan Ley I walked in these rainforests that will be flattened if the project is not stopped. #politas